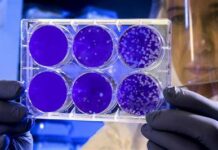
Россиянын 74 аймагында чочко тумоосу табылды

2022-жылдын эпидемиологиялык сезонунда Кыргызстанда сасык тумоонун 99 учуру катталды. Анын ичинен 34 учур чочко тумоосу.
Чочко тумоосунун А тибиндеги (H1N1) өтө жугуштуу, курч оору, капыстан пайда болуп, көп сандагы адамдарга жугат, дем алуу органдарынын жабыркашы менен мүнөздөлөт. Вирус аба аркылуу жугат.
Чочко тумоосунун белгилери:
— баш жана булчуңдардын оорушу;
— дем алуу органдары жана ооз көңдөйүнүн инфекциялары (кургак жөтөл, тамактын оорушу, дем жетпегендик);
— дене табы 38-39 градуска чейин көтөрүлөт, алсыздык;
— оорунун тез өнүгүшү, абалынын тез начарлашы;
Чочко тумоосунун вирусунан ким көбүрөөк коркунучта?
Чочко тумоосуна (H1N1) чалдыгуу боюнча коомдун эң аялуу катмарлары:
— улгайган адамдар;
— уюшулган топторго (бала бакчага, мектепке, ийримдерге ж.б.) барган балдар;
— оору тастыкталган же шектүү учурлар менен жакын байланышта болгон адамдар;
— өнөкөт оорулары бар балдар жана чоңдор;
— «чочко тумоосу» көп жайылган өлкөлөргө саякаттаган адамдар;
Чочко тумоосунан кантип сактануу керек?
— бейтаптар менен байланышуудан алыс болуңуз, эгер байланыш бар болсо, анда беткап тагыныңыз, бейтап менен аралыкты сактаңыз;
— ооруп калсаңар, үй карантининде болуңуз;
— чүчкүргөндө жана жөтөлгөндө кагаз кол аарчы менен оозуңузду жаап, аны дароо таштандыга ыргытып, колуңузду самындап жууңуз;
— бетиңизге, көзүңүзгө, мурдуңузга колуңуз менен тийбеңиз. Колду мүмкүн болушунча тез-тез жууп туруңуз, өзгөчө даараткана жана коомдук транспортту колдонгондон кийин.
Кошумчалай кетсек, Кыргызстандын медициналык мекемелеринде сасык тумоого каршы эмдөө жүргүзүлүп жатат. Саламаттыкты сактоо министрлиги сасык тумоого каршы Grippol Plus вакцинасынын 82 577 дозасын сатып алган. Ошондой эле ЮНИСЕФ аркылуу GCFLU сасык тумоого каршы вакцинасынын 45 миң дозасы сатылып алынып, гуманитардык линия аркылуу өлкөгө жеткирилип, учурда аймактарга таратылып, бекер эмдөө иштери башталды.